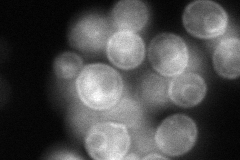
YLL061W

View description
High-affinity S-methylmethionine permease, required for utilization of S-methylmethionine as a sulfur source; has similarity to S-adenosylmethionine permease Sam3p
Localization:
Intensity:
Fold change:
Significance:
-
C’ GFP library in SD

ER23.95 -
N' NOP1pr-GFP in SD

cell periphery,ER75.7046 -
N' TEF2pr-mCherry in SD

cell periphery,vacuole149.011 -
N' NATIVEpr-GFP in SD
cell periphery,ER55.4013 -
N' TEF2pr-VC and Cyto-VN in SD

ER37.7548 -
C’ GFP library in SD+DTT

ER14.280.59Yes -
C’ GFP library in SD+H2O2

ER24.121No -
C’ GFP library in Starvation Media

ER51.382.14Yes -
C’ GFP library on the background of Pup2-DaMP

ER -
C’ GFP library on the background of CCT mutant

ER16.71480.697817Yes
